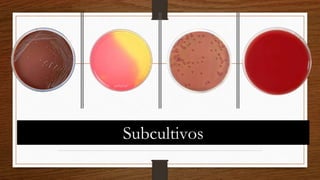
Subcultivos

Este documento proporciona información sobre hemocultivos, incluyendo su objetivo de diagnosticar infecciones del torrente sanguíneo, cómo se toman las muestras, los métodos de detección manuales y automatizados, y cómo se procesan y analizan los resultados. Explica que los hemocultivos son importantes para diagnosticar bacteriemias y fungemias y que se deben tomar muestras de dos sitios diferentes siguiendo la técnica adecuada.